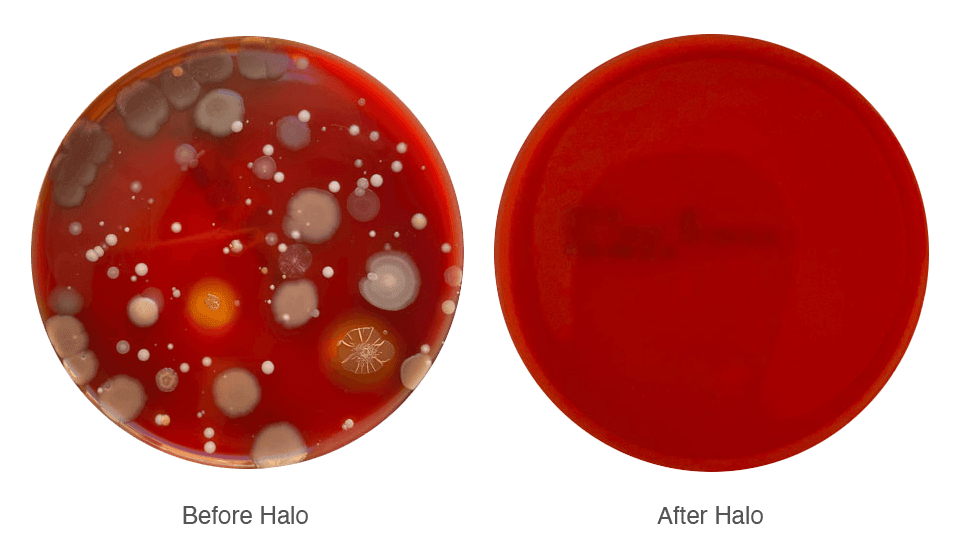

MagBak Halo - Desinfectante para teléfonos [Liquidación]
MagBak Halo - Desinfectante para teléfonos [Liquidación]
Comprados con frecuencia juntos
No se pudo cargar la disponibilidad de retiro
Halo utiliza luz UV-C para eliminar gérmenes y virus en tan solo 30 segundos. Su rápido proceso de limpieza te permite desinfectar tu teléfono cada vez que te laves las manos. Elimina el 99,9 % de los gérmenes de forma segura y eficaz.
Todas las ventas de artículos en liquidación son finales.
INCLUYE:
- MagBak Halo
- Adaptador de corriente alterna para EE. UU. 12V-3A
![MagBak Halo - Desinfectante para teléfonos [Liquidación]](http://eu.magbak.com/cdn/shop/products/halo-bw.jpg?v=1762439856&width=1445)
![MagBak Halo - Desinfectante para teléfonos [Liquidación]](http://eu.magbak.com/cdn/shop/products/mb-halo-fernangle.jpg?v=1677256584&width=1445)
![MagBak Halo - Desinfectante para teléfonos [Liquidación]](http://eu.magbak.com/cdn/shop/products/mb-halo-front.jpg?v=1677256585&width=1445)
![MagBak Halo - Desinfectante para teléfonos [Liquidación]](http://eu.magbak.com/cdn/shop/products/mb-halo-side.jpg?v=1677256585&width=1445)
~30 segundos
El proceso de limpieza rápida de Halo te permite desinfectar tu teléfono cada vez que te lavas las manos. Elimina el 99,9% de los gérmenes de forma segura y eficaz.

Sin contacto
Simplemente introduce tu teléfono para iniciar el proceso de limpieza. Tu teléfono se elevará y se te presentará para que lo recojas una vez desinfectado, evitando así la contaminación cruzada.

Se adapta a cualquier teléfono
La amplia ranura de entrada de Halo admite desde el iPhone 13 Pro Max más grande (con funda) hasta un iPhone 5 normal y corriente.

Elegancia compacta
Halo está fabricada a partir de una sola pieza de aluminio. Se somete a un proceso de granallado y anodizado para lograr un acabado impecable. Su diseño compacto permite colocarla en espacios reducidos.

Limpieza general
Tu teléfono desciende a través de un anillo de LED UV-C que garantiza la desinfección de todas las superficies.

Tecnología duradera
La implementación de Halo se basa en 20 LED UV-C controlados digitalmente. Ofrecen más de 10 000 horas de funcionamiento, no contienen mercurio y no requieren mantenimiento.

Seguridad priorizada
Halo se ha diseñado priorizando la seguridad. Los sensores garantizan que los LED UV-C se enciendan solo al detectar un teléfono. El diseño patentado de la ranura de entrada garantiza que no haya fugas de luz durante su funcionamiento.

Dimensiones
De tamaño reducido pero lo suficientemente espacioso como para albergar cualquier teléfono (con o sin funda).
Longitud : 198,4 mm (7,8 pulgadas)
Ancho : 59,3 mm (2,3 pulgadas)
Altura : 158,4 mm (6,2 pulgadas)
Longitud de apertura : 173 mm (6,8 pulgadas)
Ancho de apertura : 19 mm (0,75 pulgadas)

Presupuesto
Lo último en tecnología sanitaria.
Modelo : MBHALO
Material : Aluminio
Alimentación : 12 V CC / 3 A
Cantidad de LED UV-C : 20 × 20 mW
Vida útil del LED UV-C : más de 10 000 horas
Rango UV-C : 260 nm - 280 nm
Especificaciones sujetas a cambios. Tecnología patentada.
Seems to work perfectly. Quite noising, but not disturbing
Wife and I impressed with level of cleaning. But, if you’re not careful about how the phone is removed the status light keeps flashing rendering it incapable of accepting another phone without unplugging it.
Works well; noisier than expected.
I love this super fast phone sanitizer! I own several phone soap products and although I love them, they take several minutes to clean. This MagBak Halo is super fast. Because it's so fast, I find myself using it several times a day. I simply drop my phone through the slot while I wash my hands. My phone is usually finished cleaning the same time I finish washing my hands. Great purchase!








